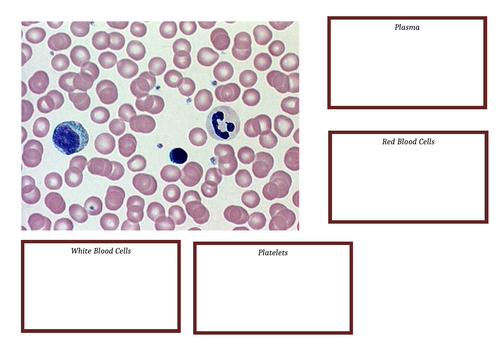
docx, 113.71 KB

A KS4 lesson on components of the blood (red blood cells, white blood cells, plasma and platelets) following the iGCSE pearson edexcel syllabus. Covering the learning objectives: 2.59 describe the composition of the blood: red blood cells, white blood cells, platelets and plasma, 2.60 understand the role of plasma in the transport of carbon dioxide, digested food, urea, hormones and heat energy and 2.61 understand how adaptations of red blood cells make them suitable for the transport of oxygen, including shape, the absence of a nucleus and the presence of haemoglobin.
Something went wrong, please try again later.
This resource hasn't been reviewed yet
To ensure quality for our reviews, only customers who have purchased this resource can review it
Report this resourceto let us know if it violates our terms and conditions.
Our customer service team will review your report and will be in touch.